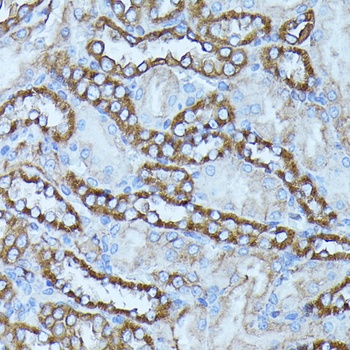
FGD1 Antibody

You have no items in your shopping cart.
All Products
- Featured
COX4I1 Antibody [orb1256931]Featured
IF, IHC, IP, WB
Human, Mouse, Rat
Rabbit
Polyclonal
Unconjugated
100 μl - Featured

- Featured

- Featured

- Featured
H3K4me2 Antibody [orb1258192]Featured
ChIP, IF, IHC, IP, WB
Human, Mouse, Other, Rat
Rabbit
Polyclonal
Unconjugated
100 μl - Featured

- Featured

- Featured

- Featured
H3R2me2a Antibody [orb1257934]Featured
ChIP, IF, IHC, IP, WB
Mouse, Rat
Rabbit
Polyclonal
Unconjugated
100 μl - Featured